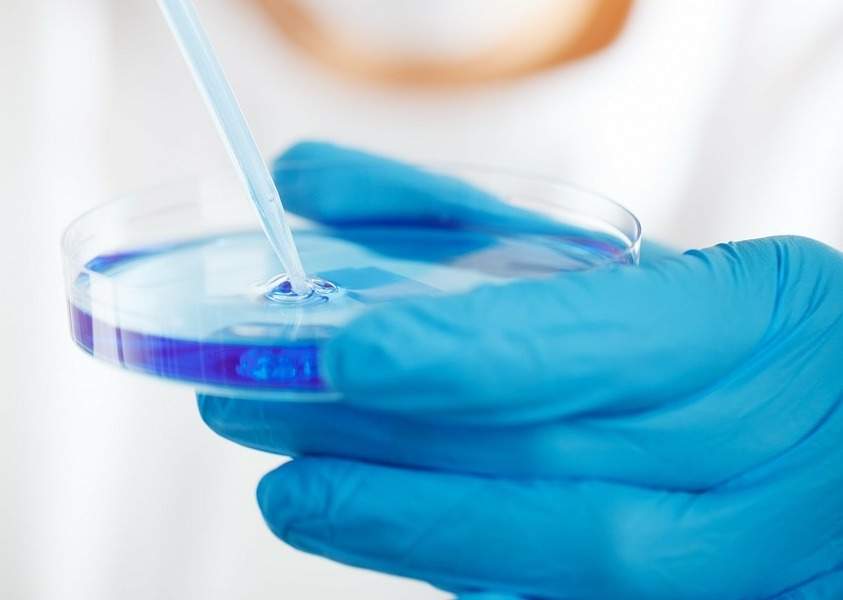

Process innovation needs to be undertaken in early R&D phase, predicts ADC Bio
ADC Biotechnology (ADC Bio) predicts that the next crucial phase of innovation to optimise and streamline production processes of ADCs will be designed at the clinical development stage by specialist, Antibody Drug Conjugates (ADC)-focused service providers. At present, a number of the larger CDMOs are focused solely on commercial scale ADC production and lack both the bandwidth and motivation for innovative manufacturing methods.
“We are still some way off having achieved fully optimised processes for the ADC supply chain. As a product class, it’s still in its infancy and there are a number of process improvements that can be made to the production of cytotoxics, including the linkers that bind them to antibodies and other elements across the supply chain. Consequently, to speed up the next generation of processes, innovators need to start considering how to improve process R&D at the early inception of a product. In particular, biotech customers may hold the key to increased adoption – as larger pharma companies might be too risk adverse – embracing innovation that delivers more efficient systems for producing their drug candidates in clinical development,” said Charlie Johnson, CEO of ADC Bio.
Diversification of therapeutic indications for ADCs, beyond what has historically been an oncology-dominated focus, is another driver stimulating the need for more flexible and efficient manufacturing. Therapeutic indications for non-cancer treatment, for example antimicrobial and anti-inflammatory targets, can require increased product volumes and manufacturing capacity. CDMOs must also have the right infrastructure and procedures in place to manufacture the compounds seamlessly across different therapeutic classes, whilst satisfying stringent regulatory requirements. The greater the ADC production levels, the higher the need for new efficiencies that reduce the overall manufacturing cost in early stage development – previously only limited volumes of candidates were needed.
“CDMOs, especially ones with specialist expertise in ADC manufacturing and an established focus on clinical phase development, should seize the industry initiative and drive much needed innovation. Suppliers with the foresight to do this will emerge long term as the most successful market players. I am confident that the next generation of ADCs will be manufactured through a more efficient and streamlined set of processes,” Johnson added.
One approach to improve supply chain efficiency is to have one CDMO undertake more parts of the supply chain – for example, bioconjugation of antibodies and cytotoxics and fill finish services, or antibody production and bioconjugation. Both have huge potential to deliver cost savings and reduced production time.
ADC Bio is an innovative biotechnology company developing new process technology to speed, simplify and significantly lower the production costs of the latest generation of anti-cancer blockbuster drugs. Its Lock-Release technology already streamlines the bioconjugation process into just four simple steps. The technology locks MAbs to resins, conjugates antibodies and cytotoxics, washes immobilised ADCs free of unwanted residuals and then releases the product. The company is also validating a downstream bioconjugation process that has potential to save several months of manufacturing time and up to a quarter of the overall costs.